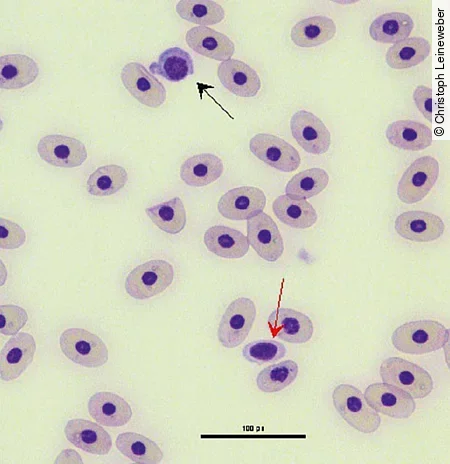
Im Blutaustrich einer Schildkröte erkennt man einen mit schwarzem Pfeil markierten Lymphozyt und einen mit rotem Pfeil markierten Thrombozyt.
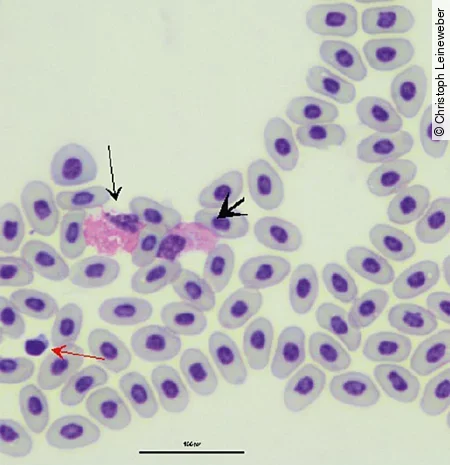
Im Blutausstrich einer Rotwangenschmuckschildkröte sieht man einen heterophilen Granulozyt, einen eosinophilen Granulozyt und einen Thrombozyt.
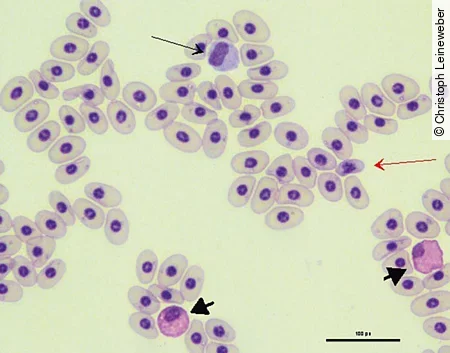
Im Blutausstrich einer Schildkröten sieht man neben den Erythrozyten auch einen Monozyt, einen Thrombozyt und einen heterophilen Granulozyt.

Inhalt

Schildkröten sind beliebte Heimtiere, die vermehrt in der tierärztlichen Praxis vorgestellt werden, sei es zum Routinecheck oder zur Abklärung von Erkrankungen. In diesem Zusammenhang ist die Blutuntersuchung neben der bildgebenden Diagnostik eine der wichtigsten diagnostischen Maßnahmen in der Reptilienmedizin, um schnell und frühzeitig eine genaue Diagnose stellen zu können. Besonders für die Diagnostik von Entzündungen und Erkrankungen der inneren Organe ist die Blutuntersuchung unerlässlich.
Wo entnehme ich das Blut?
Bei Schildkröten [Abb. 1] gibt es eine Reihe von Möglichkeiten, um eine Blutprobe zu gewinnen. Die häufigste und oft auch sicherste Methode ist die Entnahme an der dorsalen Schwanzvene (V. coccygealis dorsalis, [Abb. 2a]). Als weitere Blutentnahmestellen bieten sich der subcarapaciale Plexus [Abb. 2b], die V. jugularis [Abb. 2c] und die Brachialvene(V. brachialis) an. Die Tatsache, dass sich die Gefäße nicht wie beim Säuger gut unter der Haut darstellen lassen, erschwert die Entnahme etwas. Dazu kommt, dass die Lymphgefäße oft in unmittelbarer Nähe zu den Blutgefäßen verlaufen. Dadurch kommt es, je nach Blutentnahmetechnik, häufiger zu Lymphbeimengungen. Diese können zu einer Verfälschung diverser Laborparameter führen, was eine sichere Diagnostik erschwert.


Merke
Blutproben, die bei der Entnahme offensichtlich mit Lymphe verdünnt sind, sollten – wenn möglich – neu genommen werden.
Andernfalls müssen die Ergebnisse der Blutuntersuchung entsprechend interpretiert werden.
Wie viel Blut darf ich entnehmen?
Man geht davon aus, dass 5–8 % des Körpergewichts dem Blutvolumen der Tiere entsprechen, wovon 10 % entnommen werden können, ohne dass die Tiere dadurch beeinträchtigt werden. Als Faustregel für die maximale Entnahmemenge kann man daher sagen, dass maximal 0,7 ml/100 g KG/Blutentnahme entnommen werden dürfen. Dabei muss aber auch der klinische Zustand des Patienten berücksichtigt werden.
Merke
Stark geschwächte oder dehydrierte Tiere sollten vor der Blutentnahme erst durch Infusionen stabilisiert werden.
Welche Entnahmeröhrchen verwende ich wofür?
Die Wahl der Entnahmeröhrchen ist entscheidend für die spätere Messbarkeit und Aussagekraft der Laborparameter, denn nicht jedes Blutentnahmeröhrchen ist geeignet. Der wichtigste Punkt zuerst: EDTA als Antikoagulans führt bei Schildkröten zu einer starken Hämolyse, wodurch die Probe für eine hämatologische und klinisch-chemische Untersuchung unbrauchbar wird.
Merke
EDTA-Röhrchen sollten nur als Probenröhrchen für eine spätere PCR-Analyse verwendet werden.
Hämatologische Untersuchung
Eine hämatologische Untersuchung ist nur aus Lithium-Heparin-Vollblut möglich. Blutzellen sind sehr empfindlich und degenerieren bei längerem Transport und ungünstigen Lagerungstemperaturen schnell. Es ist daher von Vorteil, direkt nach der Blutentnahme Ausstriche anzufertigen, um die Aussagekraft des Differenzialblutbilds zu erhöhen. Dazu wird 1 Tropfen Blut im unteren Bereich auf einem Objektträger aufgebracht und mit einem 2. Objektträger, der V-förmig in einem Winkel von 30–45 ° angesetzt wird, mit einer zügigen, gleichmäßigen Bewegung ausgestrichen. Der fertige Ausstrich kann, nachdem er luftgetrocknet ist, ungefärbt ins Labor geschickt werden.
Klinisch-chemische Untersuchung
Das beste Material für eine klinisch-chemische Untersuchung ist abzentrifugiertes Serum oder Lithium-Heparin-Plasma. Findet kein Abzentrifugieren und Abpipettieren statt, kann es auch hier durch längere Lagerung zu einer Hämolyse kommen. Dies führt zum Anstieg des Kaliumspiegels und zur Freisetzung von Hämoglobin, wodurch eine photometrische Messung der klinisch-chemischen Parameter beeinträchtigt werden kann.
Merke
Für eine hämatologische und klinisch-chemische Untersuchung sollten Sie möglichst abzentrifugiertes Serum/Lithium-Heparin-Plasma, Lithium-Heparin-Vollblut und einen ungefärbten Blutausstrich einschicken [ Abb. 3].

Welche Informationen liefert die Hämatologie?
Die hämatologische Untersuchung kann wichtige Informationen im Hinblick auf Entzündungen liefern. Aufgrund der Tatsache, dass bei Reptilien alleBlutzellen kernhaltig sind, besteht nicht wie beim Säuger die Möglichkeit, die Leukozyten automatisiert zu bestimmen.
Hämatokrit
Durch Bestimmung des Hämatokrits kann eine Anämie oder Dehydratation diagnostiziert werden. Die Bestimmung des Hämatokrits erfolgt nach der Mikrohämatokrit-Methode.
Erythrozyten
Die Erythrozyten sind bei Reptilien größer als bei Säugern und haben einen zentralen, ovalen Kern. Artefakte, die wie Einschlüsse aussehen, kommen häufiger vor und beruhen zum Teil auf Trocknungsartefakten. Diese dürfen nicht mit Einschlüssen verwechselt werden, die durch bakterielle, virale oder parasitäre Infektionen verursacht wurden.
Thrombozyten
Wie die Erythrozyten sind auch die Thrombozyten kernhaltig. Ihre Form variiert sehr stark, sodass sie bei schlechtem Zellerhalt schnell mit Lymphozyten verwechselt werden können [Abb. 4]. Häufig werden auch Thrombozytenaggregate im Blutausstrich beobachtet.
Leukozyten
Eine Zählung und Differenzierung der Leukozyten erfolgt in der Regel am Blutausstrich, der mittels Diff-Quick oder Wright-Giemsa gefärbt wird. Die Leukozyten lassen sich allgemein in 2 große Gruppen differenzieren:
- mononukleäre Leukozyten: Monozyten, Lymphozyten
- Granulozyten: heterophile Granulozyten, eosinophile Granulozyten, basophile Granulozyten
Die heterophilen Granulozyten stellen sich bei Schildkröten als runde Zellen mit farblosem Zytoplasma und spindelförmiger, orangefarbener Granula dar. Diese verlieren jedoch mit zunehmendem Alter der Zellen ihre Form und Farbe. Der Kern derHeterophilen ist rund bis oval und liegt eher am Rand [Abb. 5]. Eosinophile sind durch runde, orangefarbene Granula, bläuliches Zytoplasma und einen ebenfalls randständigen Kern gekennzeichnet. Basophile sind kleiner und durch dunkelblaue bis lilafarbene Granula gekennzeichnet. Sie sind jedoch seltener im Blutausstrich zu finden als die anderen beschriebenen Zellen.
Reaktives Verhalten der Leukozyten führt häufig zu runden lila bis blauen Einschlüssen in den Zellen, die als zytotoxische Einschlüsse angesprochen werden können. Spezies, Geschlecht, Alter und physiologischer Zustand des Tieres beeinflussen die Anzahl und das Verhältnis der verschiedenen Leukozyten. Veränderungen in der Morphologie der einzelnen Zellen können jedoch Hinweise auf Infektionen geben. Verschiebungen in der Zellzahl fallen bei Reptilien geringer aus als bei Säugern und sind daher schwieriger zu interpretieren. Aber auch hier können bakterielle und parasitäre Infektionen sowie Stress zu einem Anstieg der Heterophilen führen. Die Eosinophilen sind bei parasitären Infektionen und einer Stimulation des Immunsystems erhöht.
Lymphozyten und Monozyten
Lymphozyten und Monozyten [Abb. 6] ähneln denen der Säuger. Erhöhte Lymphozytenzahlen kommen bei der Wundheilung, bei Entzündungen sowie bei parasitären und viralen Infektionen vor. Wichtig zu beachten ist aber auch, dass es physiologisch zu starken saisonalen Schwankungen in der Zellverteilung kommen kann.
Welche klinisch-chemischen Werte sind besonders wichtig?
Auch bei den klinisch-chemischen Parametern kann es abhängig von Spezies, Geschlecht, Jahreszeit und Temperatur zu Veränderungen der einzelnen Parameter kommen, die beachtet werden müssen. Die Beimengung von Lymphe führt zu erniedrigten Protein- und Kaliumwerten. Traumata bei der Blutentnahme, z. B. durch mehrfach missglückte Venenpunktion, können zu einer Erhöhung der alkalischen Phosphatase und der Kreatinkinase führen.
Merke
Aufgrund der starken Variation der Normalwerte bei einigen Spezies empfiehlt es sich, Blutuntersuchungen auch bei gesunden Tieren durchzuführen.
Im Krankheitsfall können die Ergebnisse dann besser verglichen und interpretiert werden.
Nierenerkrankungen
Harnsäure und Harnstoff
Als wichtigstes Endprodukt des Protein- und Purinstoffwechsels bei terrestrischen Arten dient die Harnsäure auch als der wichtigste Indikator für diverse Nierenerkrankungen.
Starke Erhöhungen kommen bei folgenden Erkrankungen vor:
- Gicht
- Nierenfunktionsstörungen, z. B. durch Bakteriämie oder Septikämie
- Nierennekrosen, z. B. durch nephrotoxische Medikamente (Aminoglykoside, Sulfonamide)
Durch die Fütterung tierischer Kost, physiologischerweise bei einigen Wasserschildkrötenarten, kann es auch zu einer Erhöhung der Harnsäure kommen. Erniedrigte Werte kommen im Zusammenhang mit Lebererkrankungenvor. Harnstoff spielt bei terrestrischen Arten nur eine untergeordnete Rolle, da die Werte auch bei hohen Harnsäurewerten lange Zeit im Normbereich bleiben. Bei aquatilen Arten dient auch der Harnstoff als Ausscheidungsprodukt des Proteinstoffwechsels, wodurch er hier auch eine größere Rolle für die Diagnostik von Nierenerkrankungen spielt.
Phosphat
Bei Nierenerkrankungen kommt es auch zum Anstieg des Phosphatgehalts im Blut. Eine Hyperphosphatämie kann jedoch auch durch exzessive Zufuhr mit der Nahrung, Hypervitaminose D und Hämolyse bedingt sein. Bei Jungtieren ist der Phosphatgehalt durch das Knochenwachstum physiologisch erhöht.
Lebererkrankungen
Leberenzyme
Als Indikator für Leberzellschäden dient vor allem die GLDH (Glutamatdehydrogenase). Diese kommt natürlicherweise in den Mitochondrien der Leberzellen vor und wird erst durch Zerstörung der Zellen ins Blut freigesetzt. Weitere Enzyme, die in der Leber gefunden werden, sind die ALT (Alanin-Aminotransferase), AP (alkalische Phosphatase) und AST (Aspartat-Aminotransferase). Diese Enzyme kommen jedoch nicht nur in der Leber, sondern auch in anderen Organen des Körpers vor. Sie sind daher nicht so spezifisch und müssen im Zusammenhang mit anderen Blutwerten und physiologischen Zuständen interpretiert werden. Zum Beispiel kommt die AST auch in den Muskelzellen vor, daher erfolgt eine Beurteilung immer im Zusammenhang mit dem CK-Wert (Kreatinkinase), die nur in der Muskulatur vorkommt. Durch den Vergleich bekommt man Hinweise darauf, ob die Erhöhung muskulären oder hepatogenen Ursprungs ist.
Leberfunktionsparameter
Als Leberfunktionsparameter dienen Stoffe, die natürlicherweise von der Leber synthetisiert werden und bei einer Störung der Leberfunktion erniedrigt oder erhöht sind. In diesem Zusammenhang ist vor allem die Gallensäure zu nennen. Diese kann jedoch auch durch die Fütterung, eine Verlegung der Gallengänge und Dehydratation verändert sein. Ein weiterer Funktionsparameter sind die Eiweißfraktionen im Blut, die jedoch auch durch die Nahrungsaufnahme und die Nierenfunktion beeinflusst werden. Bilirubin wird bei den meisten Reptilien nicht gebildet, da das Enzym zum Umbau aus Biliverdin fehlt. Dieser Parameter kann daher nicht zur Überprüfung der Leberfunktion herangezogen werden. Zur Diagnostik von Leberzellverfettungen kann es sinnvoll sein, den Triglyzerid- und Cholesterinspiegel im Blut zu bestimmen, da diese in diesem Zusammenhang erhöht sind. Zu beachten ist jedoch, dass diese bei Weibchen während der Eianbildung (Vitelogenese) physiologisch erhöht sind.
Weitere zukünftige Parameter
Wie die Reptilienmedizin an sich unterliegt auch die Labordiagnostik in diesem Bereich noch einem erhöhten Forschungsbedarf. Daher ist es wichtig, immer noch weitere Laborparameter zu erforschen und in der Routinediagnostik zu etablieren, um die Diagnostik und Behandlung von Reptilienerkrankungen weiter voranzutreiben. Ein Verfahren, für das immer mehr Informationen zur Verfügung stehen und das wichtige Hinweise für die Diagnostik und die Verlaufskontrolle bei verschiedenen Erkrankungen geben kann, ist die Plasmaproteinelektrophorese. Sie kann sehr sensitiv Verschiebungen der Proteinfraktionen nachweisen [Abb. 7].

Der Originalbeitrag zum Nachlesen:
Leineweber C, Marschang R E. Blutuntersuchungen bei Schildkröten. kleintier konkret 2017; 20(S01): 27 - 30. doi:10.1055/s-0042-121374
(JD)



